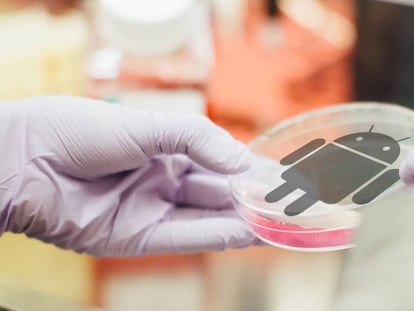

España notifica 242.440 nuevos contagios tras el día de Reyes
La incidencia acumulada a 14 días sube 147 puntos hasta los 2.722 casos

La incidencia acumulada a 14 días sube 147 puntos hasta los 2.722 casos

Se incorpora como cocinero ejecutivo global para atender las nuevas aperturas del grupo de restauración, del que es socio Rafa Nadal

El comercio alimentario supera ya las 20.000 bajas laborales por Covid

El aumento de las rentabilidades de la deuda impulsa en especial a los bancos minoristas y concentrados en España, como CaixaBank, Sabadell y Bankinter

Los tipos de interés a largo plazo suben una vez que la Fed ha sentenciado que multiplicará sus esfuerzos para luchar contra la inflación

Hay un periodo adicional en la opa hasta el 21 de enero. La operación llegará a los 2.000 millones

Tampoco se aplicará en los casos donde haya menos del 20% de alumnos contagiados
Accede a funciones que están todavía en fase beta.

Alcanza los 975 millones de euros

Está en fase de pruebas.

Google ha infringido patentes de Sonos.

Aprovéchate de las 'apps' que funcionan dentro del servicio de mensajería.
El polémico hotel de Melbourne donde Djokovic está recluido.

Es muy fácil.

La tasa de paro se reduce tres décimas, al 3,9%, gracias al descenso de la población activa

La app está dando muchos problemas con el registro de los usuarios

Funciona con Wear OS 3

Ralentiza su tendencia alcista y solo aumenta las ventas un 3,2% en diciembre

El sector señala que el éxito de las ventas este año dependerá de la variante ómicron

Será presentado el 10 de enero.

Ellos y ellas podrán llamar a sus amistades mientras hacen 'swipe'.

Apple retrasará el nuevo diseño una generación más.

Las empresas disponen de programas de financiación del ICO e ICEX, entre otros, para financiar su expansión internacional.

Los autónomos no pueden abonar ni recibir pagos en efectivo por encima de los 1.000 euros. Aunque pueden denunciar el hecho, aunque sean parte, y librarse de la sanción.

Detrás de este aumento está el encarecimiento de la electricidad La tasa en España escaló al 6,7%

Los de Mountain View facilitarán la interconexión entre dispositivos.

De un vistazo, sabrás qué tipo de mensaje acaba de llegarte.